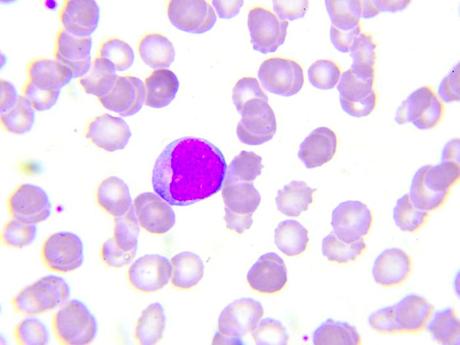
Todo lo que necesitas saber sobre la médula ósea Hay tres tipos de linfocitos. Linfocitos T, linfocitos B y células asesinas naturales.

- Cáncer
- Células madre
- Investigación de células madre
Índice
- 1 Hechos rápidos sobre la médula ósea
- 2 ¿Qué es la médula ósea?
- 2.1 Células madre de la médula ósea
- 2.2 Médula ósea roja
- 2.3 Médula ósea amarilla
- 2.4 Línea de tiempo de la médula ósea
- 3 Función
- 3.1 Sistema circulatorio
- 3.2 Hemoglobina
- 3.3 Hierro
- 3.4 Células rojas de la sangre
- 3.5 Células blancas de la sangre
- 3.5.1 1) Linfocitos
- 3.5.2 2) Monocitos
- 3.6 3) Granulocitos
- 3.6.1 4) Neutrófilos
- 3.6.2 5) Eosinófilos
- 3.6.3 6) Basófilos
- 3.7 Plaquetas
- 3.8 Sistema linfático
- 3.9 Sistema inmune
- 3.10 ¿Cómo combate el sistema inmunológico contra la infección?
- 3.11 Linfocitos B (células B)
- 3.12 Linfocitos T (células T)
- 3.13 Células asesinas naturales (NK)
- 4 Trasplantes
- 4.1 Tipos de trasplante de médula ósea.
- 4.2 Tipo de tejido
- 4.3 Pruebas de pre-trasplante
- 4.4 Recolección de médula ósea.
- 4.5 ¿Cómo se trasplanta la médula ósea?
- 4.6 Los riesgos
- 5 Enfermedades
- 6 Pruebas de medula osea
- 7 Donación
- 7.1 Quién puede donar médula ósea
- 7.2 ¿Cómo se determina una coincidencia de médula ósea?
- 7.3 ¿Qué pasa al donar médula ósea?
- 7.4 Donación de células madre de sangre periférica (PBSC)
- 7.5 Donar médula ósea
- 7.6 Recuperación
- 7.7 Salir
La médula ósea es el tejido esponjoso que se encuentra dentro de algunos de los huesos del cuerpo, incluidos los huesos de la cadera y los muslos. La médula ósea contiene células inmaduras, llamadas células madre.
Muchas personas con cáncer de la sangre, como la leucemia y el linfoma, la anemia de células falciformes y otras enfermedades que amenazan la vida, dependen de los trasplantes de médula ósea o de sangre de cordón umbilical para sobrevivir.
La médula ósea y las células sanguíneas sanas son necesarias para vivir. Cuando la enfermedad afecta la médula ósea para que ya no pueda funcionar con eficacia, un trasplante de médula o de médula podría ser la mejor opción de tratamiento; Para algunos pacientes es la única cura potencial.
Hechos rápidos sobre la médula ósea
Aquí hay algunos puntos clave sobre la médula ósea. Más detalles se encuentran en el artículo principal.
- La médula ósea produce 200 billones de glóbulos rojos nuevos cada día, junto con glóbulos blancos y plaquetas.
- La médula ósea contiene células madre mesenquimales y hematopoyéticas.
- Alrededor de 10,000 personas en los Estados Unidos son diagnosticadas cada año con enfermedades que requieren trasplantes de médula ósea.
- Varias enfermedades representan una amenaza para la médula ósea y evitan que la médula ósea convierta las células madre en células esenciales.
¿Qué es la médula ósea?
La médula ósea es un tejido suave y gelatinoso que llena las cavidades medulares, los centros de los huesos. Los dos tipos de médula ósea son la médula ósea roja, conocida como tejido mieloide, y la médula ósea amarilla o tejido adiposo.

Ambos tipos de médula ósea están enriquecidos con vasos sanguíneos y capilares.
La médula ósea produce más de 200 mil millones de células sanguíneas nuevas cada día. La mayoría de las células sanguíneas en el cuerpo se desarrollan a partir de células en la médula ósea.
Células madre de la médula ósea
La médula ósea contiene dos tipos de células madre, mesenquimales y hematopoyéticas.
La médula ósea roja consiste en un delicado tejido fibroso altamente vascularizado que contiene células madre hematopoyéticas. Estas son células madre formadoras de sangre.
La médula ósea amarilla contiene células madre mesenquimales, también conocidas como células estromales de la médula ósea. Estos producen grasa, cartílago y hueso.
Las células madre son células inmaduras que pueden convertirse en varios tipos diferentes de células.
Las células madre hematopoyéticas en la médula ósea dan lugar a dos tipos principales de células: linajes mieloides y linfoides. Estos incluyen monocitos, macrófagos, neutrófilos, basófilos, eosinófilos, eritrocitos, células dendríticas y megacariocitos o plaquetas, así como células T, células B y células asesinas naturales.
Los diferentes tipos de células madre hematopoyéticas varían en su capacidad de regeneración y potencia.
Algunos son multipotentes, oligopotentes o unipotentes, según la cantidad de células que puedan crear.
Las células madre hematopoyéticas pluripotentes tienen las siguientes propiedades:
- Renovación: Pueden reproducir otra célula idéntica a sí mismas.
- Diferenciación: pueden generar uno o más subconjuntos de células más maduras.
El proceso de desarrollo de diferentes células sanguíneas a partir de estas células madre pluripotentes se conoce como hematopoyesis.
Son estas células madre las que se necesitan en el trasplante de médula ósea.
Las células madre se dividen constantemente y producen nuevas células. Algunas células nuevas permanecen como células madre y otras pasan por una serie de etapas de maduración, como células precursoras o blastos, antes de que se formen o maduren las células sanguíneas. Las células madre se multiplican rápidamente para producir millones de células sanguíneas cada día.
Las células sanguíneas tienen una vida útil limitada. Esto es alrededor de 100-120 días para los glóbulos rojos. Ellos están siendo reemplazados constantemente. La producción de células madre sanas es vital.
Los vasos sanguíneos actúan como una barrera para evitar que las células sanguíneas inmaduras salgan de la médula ósea.
Solo las células sanguíneas maduras contienen las proteínas de membrana necesarias para unirse y pasar a través del endotelio de los vasos sanguíneos. Sin embargo, las células madre hematopoyéticas pueden atravesar la barrera de la médula ósea. Estos pueden ser cosechados de sangre periférica o circulante.
Las células madre formadoras de sangre en la médula ósea roja pueden multiplicarse y madurar en tres tipos significativos de células sanguíneas, cada una con su propio trabajo:
- Los glóbulos rojos (eritrocitos) transportan oxígeno alrededor del cuerpo
- Los glóbulos blancos (leucocitos) ayudan a combatir las infecciones y las enfermedades.
- Los glóbulos blancos incluyen linfocitos, la piedra angular del sistema inmunitario, y células mieloides que incluyen granulocitos: neutrófilos, monocitos, eosinófilos y basófilos.
- Las plaquetas (trombocitos) ayudan con la coagulación después de una lesión. Las plaquetas son fragmentos del citoplasma de los megacariocitos, otra célula de la médula ósea.
Una vez que están maduras, estas células sanguíneas pasan de la médula a la corriente sanguínea, donde realizan funciones importantes necesarias para mantener el cuerpo vivo y saludable.
Las células madre mesenquimales se encuentran en la cavidad de la médula ósea. Se diferencian en varios linajes estromales, tales como:
- condrocitos (cartilago generacion)
- osteoblastos (formación ósea)
- osteoclastos
- adipocitos (tejido adiposo)
- miocitos (músculo)
- macrófagos
- células endoteliales
- fibroblastos
Médula ósea roja
La médula ósea roja produce todos los glóbulos rojos y plaquetas en adultos humanos y alrededor del 60 al 70 por ciento de los linfocitos. Otros linfocitos comienzan su vida en la médula ósea roja y se forman completamente en los tejidos linfáticos, incluidos el timo, el bazo y los ganglios linfáticos.
Junto con el hígado y el bazo, la médula ósea roja también desempeña un papel en la eliminación de los glóbulos rojos viejos.
Médula ósea amarilla
La médula ósea amarilla actúa principalmente como una tienda de grasas. Ayuda a proporcionar sustento y mantener el entorno correcto para que el hueso funcione. Sin embargo, bajo condiciones particulares, como la pérdida severa de sangre o la fiebre , la médula amarilla puede volver a la médula roja.
La médula amarilla tiende a ubicarse en las cavidades centrales de los huesos largos, y generalmente está rodeada por una capa de médula roja con trabéculas largas (estructuras en forma de haz) dentro de un marco reticular similar a una esponja.
Línea de tiempo de la médula ósea
Antes del nacimiento, la médula ósea se desarrolla primero en la clavícula hacia el final del desarrollo fetal. Se vuelve activo unas 3 semanas después. La médula ósea se hace cargo del hígado como el principal órgano hematopoyético a las 32 a 36 semanas de gestación.
La médula ósea permanece roja hasta alrededor de los 7 años, ya que la necesidad de una nueva formación continua de sangre es alta. A medida que el cuerpo envejece, la médula roja se reemplaza gradualmente por tejido graso amarillo. Los adultos tienen un promedio de aproximadamente 2.6 kg (5.7 lbs) de médula ósea, aproximadamente la mitad de los cuales es de color rojo.
En adultos, la concentración más alta de médula roja está en los huesos de las vértebras, las caderas (ilion), el esternón, las costillas, el cráneo y en los extremos metafisario y epifisario de los huesos largos del brazo (húmero) y la pierna ( fémur y tibia). Todos los demás huesos esponjosos o esponjosos y las cavidades centrales de los huesos largos están rellenos de médula amarilla.
Función
La mayoría de los glóbulos rojos, las plaquetas y la mayoría de los glóbulos blancos se forman en la médula roja. La médula ósea amarilla produce grasa, cartílago y hueso.

Los glóbulos blancos sobreviven de unas pocas horas a unos pocos días, las plaquetas durante unos 10 días y los glóbulos rojos durante unos 120 días. Estas células deben ser reemplazadas constantemente por la médula ósea, ya que cada célula sanguínea tiene una expectativa de vida establecida.
Ciertas condiciones pueden desencadenar la producción adicional de células sanguíneas. Esto puede suceder cuando el contenido de oxígeno de los tejidos corporales es bajo, si hay pérdida de sangre o anemia, o si disminuye el número de glóbulos rojos. Si esto sucede, los riñones producen y liberan eritropoyetina, una hormona que estimula la médula ósea para producir más glóbulos rojos.
La médula ósea también produce y libera más glóbulos blancos en respuesta a las infecciones y más plaquetas en respuesta al sangrado. Si una persona experimenta una pérdida de sangre grave, la médula ósea amarilla puede activarse y transformarse en médula ósea roja.
La médula ósea saludable es importante para una variedad de sistemas y actividades.
Sistema circulatorio
El sistema circulatorio toca todos los órganos y sistemas del cuerpo. Se trata de una serie de células diferentes con una variedad de funciones. Los glóbulos rojos transportan oxígeno a las células y tejidos, las plaquetas se transportan en la sangre para ayudar a coagular la sangre después de la lesión y los glóbulos blancos se transportan a sitios de infección o lesión.
Hemoglobina
La hemoglobina es la proteína en los glóbulos rojos que les da su color. La hemoglobina recolecta oxígeno en los pulmones, lo transporta en los glóbulos rojos y libera oxígeno a tejidos como el corazón, los músculos y el cerebro. El dióxido de carbono (CO 2 ), un producto de desecho de la respiración, también se elimina con la hemoglobina y se envía de vuelta a los pulmones para ser exhalado.
Hierro
El hierro es un nutriente importante para la fisiología humana. Se combina con proteínas para producir la hemoglobina en los glóbulos rojos y es esencial en la producción de glóbulos rojos (eritropoyesis). El cuerpo almacena hierro en el hígado, el bazo y la médula ósea. La mayor parte del hierro que se necesita cada día para producir hemoglobina proviene del reciclaje de glóbulos rojos viejos.
Células rojas de la sangre
La producción de glóbulos rojos se llama eritropoyesis. Se tarda aproximadamente 7 días para que una célula madre comprometida se convierta en un glóbulo rojo completamente funcional. A medida que los glóbulos rojos envejecen, se vuelven menos activos y más frágiles.
Los glóbulos rojos que envejecen se eliminan o se comen por un tipo de glóbulos blancos, o macrófagos, en un proceso conocido como fagocitosis. El contenido de estas células se libera en la sangre. El hierro liberado en este proceso se lleva a la médula ósea para la producción de nuevos glóbulos rojos o al hígado u otros tejidos para su almacenamiento.
Leer ahora > El fortalecimiento de las células grasas ofrece un nuevo tratamiento potencial contra la leucemiaNormalmente, alrededor del 1 por ciento de los glóbulos rojos totales del cuerpo se reemplazan todos los días. En una persona sana, alrededor de 200 mil millones de glóbulos rojos se producen cada día.
Células blancas de la sangre
La médula ósea produce muchos tipos de glóbulos blancos. Estos son necesarios para un sistema inmunológico saludable. Previenen y combaten las infecciones.
Los principales tipos de glóbulos blancos, o leucocitos, son:
1) Linfocitos
Los linfocitos se producen en la médula ósea. Producen anticuerpos naturales para combatir las infecciones causadas por virus que ingresan al cuerpo a través de la nariz, la boca u otra membrana mucosa, o a través de cortes y rasguños. Las células específicas reconocen la presencia de invasores extraños (antígenos) que entran al cuerpo y envían una señal a otras células para atacar a los antígenos.
El número de linfocitos aumenta en respuesta a estas invasiones. Hay dos tipos principales de linfocitos: los linfocitos B y los linfocitos T.
2) Monocitos
Los monocitos se producen en la médula ósea. Los monocitos maduros tienen una esperanza de vida en la sangre de solo 3 a 8 horas, pero cuando se mueven hacia los tejidos, se convierten en células más grandes llamadas macrófagos. Los macrófagos pueden sobrevivir en los tejidos durante largos períodos de tiempo en los que engullen y destruyen bacterias, algunos hongos, células muertas y otros materiales extraños al cuerpo.
3) Granulocitos
Granulocito es el nombre familiar o colectivo dado a tres tipos de glóbulos blancos: neutrófilos, eosinófilos y basófilos. El desarrollo de un granulocito puede tomar dos semanas, pero este tiempo se acorta cuando hay un aumento de la amenaza, como una infección bacteriana.
La médula ósea almacena una gran reserva de granulocitos maduros. Por cada granulocito que circula dentro de la sangre, puede haber entre 50 y 100 células esperando en la médula para ser liberadas en el torrente sanguíneo. Como resultado, la mitad de los granulocitos en el torrente sanguíneo pueden estar disponibles para combatir activamente una infección en el cuerpo dentro de las 7 horas posteriores a la detección de una infección.
Una vez que un granulocito ha salido de la sangre, normalmente no regresa. Un granulocito puede sobrevivir en los tejidos durante 4 a 5 días, dependiendo de las condiciones, pero solo sobrevive durante unas pocas horas en la circulación.
4) Neutrófilos
Los neutrófilos son los granulocitos más comunes. Pueden atacar y destruir bacterias y virus.
5) Eosinófilos
Los eosinófilos participan en la lucha contra muchos tipos de infecciones parasitarias y contra las larvas de gusanos parásitos y otros organismos. También están involucrados en algunas reacciones alérgicas.
6) Basófilos
Los basófilos son los menos comunes de los glóbulos blancos y responden a varios alérgenos que causan la liberación de histaminas, heparina y otras sustancias.
La heparina es un anticoagulante. Evita que la sangre se coagule. Las histaminas son vasodilatadores que causan irritación e inflamación. La liberación de estas sustancias hace que un patógeno sea más permeable, y permite que los glóbulos blancos y las proteínas ingresen en los tejidos para atacar al patógeno.
La irritación e inflamación en los tejidos afectados por un alérgeno es parte de la reacción observada en la fiebre del heno, algunas formas de asma, urticaria y, en su forma más grave, el shock anafiláctico.
Plaquetas
La médula ósea produce plaquetas en un proceso conocido como trombopoyesis. Las plaquetas son necesarias para que la sangre se coagule y para que se formen coágulos, para detener el sangrado.
La pérdida repentina de sangre desencadena la actividad plaquetaria en el sitio de una lesión o herida. Aquí, las plaquetas se agrupan y se combinan con otras sustancias para formar fibrina. La fibrina tiene una estructura similar a un hilo y forma una costra o coágulo externo.
La deficiencia de plaquetas hace que el cuerpo se lastime y sangra más fácilmente. La sangre puede no coagularse bien con una herida abierta, y puede haber un mayor riesgo de sangrado interno si el recuento de plaquetas es muy bajo.
Sistema linfático
El sistema linfático está formado por órganos linfáticos como la médula ósea, las amígdalas, el timo, el bazo y los ganglios linfáticos.
Todos los linfocitos se desarrollan en la médula ósea a partir de células inmaduras llamadas células madre. Los linfocitos que maduran en la glándula timo (detrás del esternón) se llaman células T. Aquellos que maduran en la médula ósea o en los órganos linfáticos se denominan células B.
Sistema inmune
El sistema inmunológico protege al cuerpo de las enfermedades. Mata los microorganismos no deseados, como las bacterias y los virus, que pueden invadir el cuerpo.
¿Cómo combate el sistema inmunológico contra la infección?
Las glándulas pequeñas llamadas ganglios linfáticos están dispersas por todo el cuerpo. Una vez que se producen linfocitos en la médula, viajan a los ganglios linfáticos. Los linfocitos luego pueden viajar entre cada nodo a través de canales linfáticos que se encuentran en grandes conductos de drenaje que se vacían en un vaso sanguíneo. Los linfocitos entran en la sangre a través de estos conductos.
Tres tipos principales de linfocitos juegan una parte importante del sistema inmunológico:
Linfocitos B (células B)
Estas células se originan a partir de células madre hematopoyéticas en la médula ósea en mamíferos.
Linfocitos T, linfocitos B y células asesinas naturales.
Las células B expresan receptores de células B (BCR) en la superficie de las células. Estos permiten que la célula se adhiera a un antígeno en la superficie de un microbio invasor u otro agente antigénico.
Por esta razón, las células B se conocen como células presentadoras de antígenos, ya que alertan a otras células del sistema inmunitario de un microbio invasor.
Las células B también secretan anticuerpos que se adhieren a la superficie de los microbios que causan infecciones. Estos anticuerpos tienen forma de Y, y cada uno es similar a un “bloqueo” especializado en el que se ajusta una “clave” de antígeno correspondiente. Como tal, cada anticuerpo en forma de Y reacciona a un microbio diferente, lo que desencadena una respuesta mayor del sistema inmunitario con el objetivo de combatir la infección.
En algunas circunstancias, las células B identifican erróneamente las células normales del cuerpo humano como antígenos que requieren una respuesta del sistema inmunológico. Este es el mecanismo que se encuentra detrás del desarrollo de enfermedades autoinmunes como la esclerosis múltiple , la esclerodermia y la diabetes tipo 1.
Linfocitos T (células T)
Estas células se llaman así porque maduran en el timo, un órgano pequeño en la parte superior del tórax, justo detrás del esternón (algunas células T maduran en las amígdalas). Hay muchos tipos diferentes de células T, y realizan una serie de funciones como parte de la inmunidad adaptada mediada por células. Las células T ayudan a las células B a producir anticuerpos contra bacterias invasoras, virus u otros microbios.
A diferencia de las células B, algunas células T envuelven y destruyen patógenos directamente, luego de unirse al antígeno en la superficie del microbio.
Las células T asesinas naturales, que no deben confundirse con las células asesinas naturales del sistema inmunitario innato, superan los sistemas inmunitarios adaptativos e innatos. Las células NKT reconocen los antígenos presentados de manera diferente a muchos otros antígenos, y pueden realizar las funciones de las células T auxiliares y las células T citotóxicas. También pueden reconocer y eliminar algunas células tumorales .
Células asesinas naturales (NK)
Estos son un tipo de linfocito que ataca directamente a las células que han sido infectadas por un virus.
Trasplantes
Un trasplante de médula ósea se puede utilizar por varias razones.
- Puede reemplazar la médula ósea enferma que no funciona con una médula ósea que funciona de manera saludable. Esto se usa para afecciones como leucemia, anemia aplásica y anemia de células falciformes.
- Puede regenerar un nuevo sistema inmunológico que combatirá la leucemia existente o residual u otros cánceres que no se eliminan con la quimioterapia o la radiación.
Puede reemplazar la médula ósea y restablecer su función normal después de administrar altas dosis de quimioterapia o radiación para tratar una enfermedad maligna. - Puede reemplazar la médula ósea con una médula ósea que funciona genéticamente saludable para prevenir un daño mayor de un proceso de enfermedad genética, como el síndrome de Hurler y la adrenoleucodistrofia.
Las células madre se encuentran principalmente en cuatro lugares:
- un embrión
- médula ósea
- sangre periférica, que se encuentra en los vasos sanguíneos de todo el cuerpo
- sangre del cordón umbilical, que se encuentra en el cordón umbilical y se recolecta después del nacimiento.
Las células madre para el trasplante se obtienen de cualquiera de estos, excepto el feto.

El trasplante de células madre hematopoyéticas implica la infusión intravenosa de células madre recolectadas de médula ósea, sangre periférica o sangre del cordón umbilical.
Esto se utiliza para restablecer la función hematopoyética en pacientes cuya médula ósea o sistema inmunitario está dañado o defectuoso.
Más de 50,000 primeros procedimientos de trasplante de células madre hematopoyéticas, 28,000 procedimientos de trasplante autólogo y 21,000 procedimientos de trasplante alogénico se realizan cada año en todo el mundo, según el primer informe de la Red Mundial para el Trasplante de Sangre y Médula.
Este número continúa aumentando en un 10 a 20 por ciento anual. Las reducciones en el daño a los órganos, la infección y la enfermedad grave y aguda de injerto contra huésped (EICH) parecen contribuir a mejorar los resultados.
En un estudio de 854 pacientes que habían sobrevivido al menos 2 años después del trasplante autólogo de células madre hematopoyéticas (TCMH) por neoplasia maligna hematológica, el 68.8 por ciento seguía vivo 10 años después del trasplante.
El trasplante de médula ósea es el tratamiento principal para las afecciones que amenazan la capacidad de funcionamiento de la médula ósea, como la leucemia.
Un trasplante puede ayudar a reconstruir la capacidad del cuerpo para producir células sanguíneas y llevar su número a niveles normales. Las enfermedades que pueden tratarse con un trasplante de médula ósea incluyen enfermedades cancerosas y no cancerosas.
Las enfermedades cancerosas pueden o no involucrar específicamente a las células sanguíneas, pero el tratamiento del cáncer puede destruir la capacidad del cuerpo para fabricar nuevas células sanguíneas.
Una persona con cáncer normalmente se someterá a quimioterapia antes del trasplante. Esto eliminará la médula comprometida.
Un donante compatible, en la mayoría de los casos un miembro cercano de la familia, luego se les extrae la médula ósea y se prepara para el trasplante
Tipos de trasplante de médula ósea.
Los tipos de trasplante de médula ósea incluyen:
- Trasplante autólogo: los pacientes reciben sus propias células madre extraídas de su sangre periférica o del cordón para reponer la médula ósea
- Trasplante singénico: los pacientes reciben células madre de su gemelo idéntico
- Trasplante alogénico: los pacientes reciben células madre compatibles de su hermano, padre o un donante no relacionado
- Trasplante haploidéntico: una opción de tratamiento para aproximadamente el 70% de los pacientes que no tienen un donante compatible idéntico a HLA
- Sangre del cordón umbilical: un tipo de trasplante alogénico. Las células madre se extraen del cordón umbilical de un bebé recién nacido justo después del nacimiento. Las células madre se congelan y almacenan hasta que se necesitan para un trasplante. Las células de la sangre del cordón umbilical son muy inmaduras, por lo que existe una menor necesidad de apareamiento, pero los recuentos sanguíneos tardan más en recuperarse.
Tipo de tejido
El tipo de tejido de una persona se define como el tipo de antígeno leucocitario humano (HLA) en la superficie de la mayoría de las células de su cuerpo. HLA es una proteína o marcador que el cuerpo usa para ayudarlo a determinar si la célula pertenece o no al cuerpo.
Leer ahora > El fortalecimiento de las células grasas ofrece un nuevo tratamiento potencial contra la leucemiaPara verificar si el tipo de tejido es compatible, los médicos evalúan cuántas proteínas coinciden en la superficie de las células sanguíneas del donante y del receptor. Hay millones de tipos diferentes de tejidos, pero algunos son más comunes que otros.
El tipo de tejido se hereda y los tipos se transmiten de cada padre. Esto significa que un familiar tendrá más probabilidades de tener un tipo de tejido coincidente.
Sin embargo, si los familiares no pueden encontrar un donante de médula ósea adecuado, los médicos tratarán de encontrar a alguien con un tipo de tejido compatible en el registro de donantes de médula ósea.
Pruebas de pre-trasplante
Se realizan varias pruebas antes del trasplante de médula ósea para identificar cualquier problema potencial.
Las pruebas incluyen:
- tipificación de tejidos y una variedad de análisis de sangre
- radiografía de pecho
- pruebas de funcion pulmonar
- tomografías computarizadas o catálisis
- pruebas de función cardíaca que incluyen un electrocardiograma y un ecocardiograma (ECG)
- biopsia de médula ósea
- encuesta esquelética
Además, se necesita un examen dental completo antes de un trasplante de médula ósea, para reducir el riesgo de infección. También se tomarán otras precauciones antes del trasplante para reducir el riesgo de infección del paciente.
Recolección de médula ósea.
La médula ósea se puede obtener para su examen mediante biopsia de médula ósea y aspiración de médula ósea.
La extracción de médula ósea se ha convertido en un procedimiento relativamente rutinario. Generalmente se aspira desde las crestas ilíacas posteriores mientras el donante está bajo anestesia regional o general.
También se puede extraer del esternón y de la tibia superior en niños, ya que todavía contiene una cantidad sustancial de médula ósea roja.
El médico insertará una aguja en el hueso, generalmente en la cadera, y extraerá algo de la médula ósea. Luego se almacena y se congela.
Las pautas establecidas por el Programa Nacional de Donantes de Médula Ósea (NMDP) limitan el volumen de médula ósea extraída a 15 ml / kg de peso del donante. Se requiere una dosis de 1 x 103 y 2 x 108 células mononucleares de médula ósea por kilogramo para establecer el injerto en trasplantes de médula ósea autólogos y alogénicos, respectivamente.
Las complicaciones relacionadas con la extracción de médula ósea son raras. Implican problemas relacionados con la anestesia, la infección y el sangrado.
Otra forma de evaluar la función de la médula ósea es administrar ciertos medicamentos que estimulan la liberación de células madre de la médula ósea a la sangre circulante. Luego se obtiene la muestra de sangre y las células madre se aíslan para un examen microscópico. En los recién nacidos, las células madre pueden recuperarse del cordón umbilical.
¿Cómo se trasplanta la médula ósea?
Antes del trasplante, se puede administrar quimioterapia, radiación o ambos. Esto se puede hacer de dos maneras:
- Tratamiento ablativo (mieloablativo): se administran altas dosis de quimioterapia, radiación o ambas para matar cualquier célula cancerosa. Esto también mata toda la médula ósea sana que permanece, y permite que nuevas células madre crezcan en la médula ósea.
- Tratamiento de intensidad reducida o un mini trasplante: los pacientes reciben dosis más bajas de quimioterapia y radiación antes del trasplante. Esto permite que los pacientes mayores y aquellos con otros problemas de salud tengan un trasplante.
Un trasplante de células madre generalmente se realiza después de completar la quimioterapia y la radiación.
La infusión de médula ósea o sangre periférica es un proceso relativamente simple que se realiza en la cabecera del paciente. El producto de la médula ósea se infunde a través de una vena central a través de un tubo intravenoso durante un período de varias horas. Los productos autólogos son casi siempre crioconservados; se descongelan al lado de la cama y se infunden rápidamente durante un período de varios minutos.
Después de ingresar al torrente sanguíneo, las células madre hematopoyéticas viajan a la médula ósea. Allí, comienzan a producir nuevos glóbulos blancos, glóbulos rojos y plaquetas en un proceso conocido como injerto. El injerto generalmente ocurre de 2 a 4 semanas después del trasplante.
Se ha observado una toxicidad mínima en la mayoría de los casos. Las infusiones de médula ósea no coincidentes ABO a veces pueden provocar reacciones hemolíticas. El dimetilsulfóxido (DMSO), que se usa para la crioconservación de células madre, puede provocar enrojecimiento facial, sensación de cosquilleo en la garganta y un sabor fuerte en la boca (el sabor del ajo). En raras ocasiones, el DMSO puede causar bradicardia, dolor abdominal, encefalopatía o convulsiones e insuficiencia renal.
Para evitar el riesgo de encefalopatía, que se produce con dosis superiores a 2 g / kg / día de DMSO, se infunden infusiones de células madre que superan los 500 ml durante 2 días, y la tasa de infusión se limita a 20 ml / min.
Los médicos revisan regularmente los recuentos sanguíneos. La recuperación completa de la función inmunitaria puede llevar varios meses para los receptores autólogos de trasplantes y de 1 a 2 años para los pacientes que reciben trasplantes alogénicos o singénicos.
Los análisis de sangre confirmarán que se están produciendo nuevas células sanguíneas y que el cáncer no ha regresado. La aspiración de médula ósea también puede ayudar a los médicos a determinar qué tan bien está funcionando la nueva médula.
Los riesgos
Las complicaciones asociadas con el TCMH incluyen efectos tempranos y tardíos.
Los problemas de inicio temprano incluyen:
- mucositis
- cistitis hemorrágica
- pancitopenia severa y prolongada
- infección
- GVHD (enfermedad de injerto contra huésped)
- falla de injerto
- complicaciones pulmonares
- enfermedad venooclusiva hepática
- microangiopatía trombótica
Los problemas de inicio tardío incluyen:
- GVHD crónica
- efectos oculares
- efectos endocrinos
- efectos pulmonares
- efectos musculoesqueléticos
- efectos neurologicos
- efectos inmunes
- infección
- insuficiencia cardiaca congestiva
- malignidad subsiguiente
Los principales riesgos incluyen una mayor susceptibilidad a las infecciones, anemia, falla del injerto, dificultad respiratoria y exceso de líquido, lo que puede conducir a neumonía y disfunción hepática.
Un desajuste entre los tejidos del donante y el receptor puede provocar una reacción inmune entre las células del huésped y las células del injerto.
Cuando las células de injerto atacan a las células del huésped, el resultado es una condición peligrosa llamada enfermedad de injerto contra huésped (GVHD, por sus siglas en inglés), que puede ser aguda o crónica y puede manifestarse como una erupción cutánea, enfermedad gastrointestinal o enfermedad hepática. El riesgo de GVHD se puede minimizar mediante una cuidadosa combinación de tejidos.
Incluso cuando la coincidencia de antígeno del donante es idéntica, aproximadamente el 40 por ciento de los receptores aún desarrollan GVHD, aumentando de 60 a 80 por ciento cuando solo un antígeno no coincide. Debido al peligro de esta complicación, los trasplantes autólogos se realizan con más frecuencia.
El trasplante de médula ósea no se recomendó previamente para pacientes mayores de 50 años, debido a una mayor tasa de mortalidad y morbilidad y un aumento de la incidencia de GVHD en los mayores de 30 años. Sin embargo, muchos centros de trasplantes han realizado exitosos trasplantes de médula ósea en pacientes que superan los 50 años.
Hay poco riesgo para aquellos que donan, porque generan nueva médula para reemplazar lo que se ha eliminado. Sin embargo, existe un ligero riesgo de infección y puede producirse una reacción a la anestesia con cualquier procedimiento quirúrgico.
Enfermedades
Como la médula ósea afecta a muchos sistemas del cuerpo, un problema puede provocar una amplia gama de enfermedades, incluidos los cánceres que afectan la sangre.
Una serie de enfermedades representan una amenaza para la médula ósea porque evitan que la médula ósea convierta las células madre en células esenciales.
Se sabe que la leucemia, la enfermedad de Hodgkin y otros cánceres de linfoma dañan la capacidad productiva de la médula y destruyen las células madre.
Un examen de médula ósea puede ayudar a diagnosticar:

- leucemia
- mieloma múltiple
- enfermedad de Gaucher
- casos inusuales de anemia
- Otras enfermedades hematológicas.
Un número creciente de enfermedades puede tratarse con transferencia de células madre hematopoyéticas (TCMH).
Más de la mitad de los trasplantes autólogos se realizan para tratar el mieloma múltiple y el linfoma no Hodgkin. La mayoría de los trasplantes alogénicos se realizan para los cánceres hematológicos y linfoides.
Cada 4 minutos, alguien recibe un diagnóstico de cáncer de la sangre. Un trasplante de médula ósea es a menudo la mejor oportunidad para sobrevivir.
Alrededor del 30 por ciento de los pacientes pueden encontrar un donante compatible en sus familias, pero el 70 por ciento, o alrededor de 14,000 cada año, dependen de la médula donada por alguien no relacionado.
El HSCT autólogo se utiliza actualmente para tratar:
- mieloma múltiple
- no linfoma de Hodgkin
- linfoma de Hodgkin
- leucemia mieloide aguda
- neuroblastoma
- tumores de células germinales
- Trastornos autoinmunes, como lupus eritematoso sistémico y esclerosis sistémica
- amilosis
El HSCT alogénico se utiliza para tratar:
- leucemia mieloide aguda
- leucemia linfoblástica aguda
- leucemia mieloide crónica
- leucemia linfocítica crónica
- trastornos mieloproliferativos
- síndromes mielodisplásicos
- mieloma múltiple
- no linfoma de Hodgkin
- linfoma de Hodgkin
- anemia aplásica
- aplasia pura de glóbulos rojos
- hemoglobinuria paroxística nocturna
- anemia de fanconi
- talasemia mayor
- anemia falciforme
- inmunodeficiencia combinada severa (SCID)
- síndrome de Wiskott-Aldrich
- linfohistiocitosis hemofagocítica
- trastornos genéticos relacionados con el metabolismo, como la mucopolisacaridosis
- enfermedad de Gaucher, leucodistrofias metacromáticas y adrenoleucodistrofias
- epidermolisis bullosa
- neutropenia congénita severa
- síndrome de Shwachman-Diamond
- anemia diamante-blackfan
- deficiencia de adhesión de leucocitos
El HSCT también puede ayudar a tratar:
- cáncer de mama, aunque esto no está confirmado
- cáncer testicular, en algunos pacientes en etapa temprana.
- Algunos trastornos genéticos inmunológicos o hematopoyéticos.
En ocasiones, se necesitan trasplantes de médula ósea después de ciertos tratamientos, como la quimioterapia de alta dosis y la radioterapia , que se usan para tratar el cáncer. Estos tratamientos tienden a dañar las células madre sanas y también a destruir las células cancerosas.
Pruebas de medula osea
Las pruebas de médula ósea pueden ayudar a diagnosticar ciertas enfermedades, especialmente aquellas relacionadas con la sangre y los órganos formadores de sangre. Las pruebas proporcionan información sobre las reservas de hierro y la producción de sangre.
La aspiración de médula ósea utiliza una aguja hueca para extraer una pequeña muestra (aproximadamente 1 ml) de médula ósea para examinarla con un microscopio.
La aguja generalmente se inserta en la cadera o el esternón en adultos y en la parte superior de la tibia (el hueso más grande de la pierna) en niños y se usa succión para extraer la muestra.
La aspiración de médula ósea se realiza típicamente cuando se indica mediante análisis de sangre previos y es particularmente útil para proporcionar información sobre varias etapas de células sanguíneas inmaduras.
Donación
Hay dos tipos principales de donación de médula ósea.

El primero implica la extracción de la médula ósea de la parte posterior del hueso pélvico.
El segundo método, más común, se llama donación de células madre de sangre periférica (PBSC). Esto implica filtrar las células madre directamente de la sangre. Son estas células madre sanguíneas, en lugar de la médula ósea, las que son necesarias para el tratamiento de los cánceres de la sangre y otras enfermedades.
Cuando una persona se une a un registro de donación de médula ósea, está de acuerdo en donar utilizando el método que el médico del paciente considere apropiado.
En términos de costos, el costo de hacer una donación de médula sanguínea generalmente está cubierto por el NMDP o el seguro médico del paciente. Los donantes nunca pagan por donar, y nunca se les paga por donar.
Leer ahora > El fortalecimiento de las células grasas ofrece un nuevo tratamiento potencial contra la leucemiaEl riesgo para un donante es mínimo. Más del 99 por ciento de los donantes se recuperan completamente después del procedimiento. Con la donación de médula sanguínea, el mayor riesgo implica el uso de anestesia durante el procedimiento en sí.
Con la donación de PBSC, el procedimiento en sí, que consiste en filtrar la sangre a través de una máquina, no se considera peligroso.
La probabilidad de encontrar un donante de médula ósea adecuado varía de 66 a 93 por ciento, dependiendo de la etnia.
Quién puede donar médula ósea
Las siguientes son algunas pautas generales para la donación de médula ósea según lo recomendado por el Programa Nacional de Donantes de Médula Ósea (NMDP).
Las directrices tienen como objetivo proteger la salud y la seguridad del donante y el receptor. Se alienta a los donantes a ponerse en contacto con su centro local de NMDP para obtener detalles específicos y para discutir las donaciones con su equipo de atención médica.
- Para ser incluido en el registro, los posibles donantes deben ser saludables y tener entre 18 y 60 años de edad.
- Si se combina con una persona que necesita un trasplante, cada donante debe pasar un examen médico y estar libre de infección antes de donar.
- Las personas que usaron medicamentos normalmente pueden donar médula ósea, siempre y cuando estén sanos y cualquier condición médica que tengan esté bajo control al momento de la donación.
Los medicamentos aceptables incluyen píldoras anticonceptivas, medicamentos para la tiroides. antihistamínicos, antibióticos , gotas para los ojos recetadas y medicamentos tópicos, como cremas para la piel. Se permiten los medicamentos contra la ansiedad y los antidepresivos siempre que la condición esté bajo control.
Donar no es posible:
- durante el embarazo
- por cualquier persona que use drogas intravenosas que no estén recetadas por un médico
- si la persona ha tenido un análisis de sangre positivo para hepatitis B o hepatitis C
por personas con afecciones médicas específicas, como la mayoría de los tipos de cáncer o ciertas afecciones cardíacas
Las personas con enfermedad de Lyme , malaria o tatuajes o piercings recientes deben esperar al menos un año antes de donar médula ósea.
¿Cómo se determina una coincidencia de médula ósea?
Después de registrarse para donar, la persona realizará una prueba de tipificación HLA, que se utiliza para hacer coincidir a los pacientes con posibles donantes.
Su tipo de HLA se agregará a una base de datos de posibles donantes, y un médico buscará en el registro para encontrar una coincidencia para su paciente.
Las proteínas de las células sanguíneas se compararán para ver si son similares a las del receptor. Se contactará al posible donante si hay una coincidencia.
Cuanto más similar sea el tipo de tejido del donante al del paciente, mayores serán las probabilidades de que el cuerpo del paciente acepte el trasplante.
Bone Marrow Donors Worldwide (BMDW) es una base de datos colectiva de 59 registros en 43 países y 37 registros de sangre de cordón umbilical de 21 países; 26.35 millones de donantes potenciales de células madre y 687 mil unidades de sangre de cordón umbilical estaban disponibles a partir de septiembre de 2015. 19,20 Las búsquedas preliminares a través del NMDP también exploran el BMDW.
¿Qué pasa al donar médula ósea?
Los siguientes estudios se realizan de forma rutinaria en donantes de células madre hematopoyéticas:
- historia y examen fisico
- estudios de creatinina sérica, electrolitos y función hepática
- estudios serológicos para citomegalovirus (CMV), virus del herpes , ARN del VIH, anticuerpos contra el VIH, virus de la hepatitis B y C, virus linfotrópico humano de células T 1/2 (HTLV-I / II) y sífilis (VDRL); En las donaciones autólogas, no se requieren pruebas de CMV y VDRL.
- tipo de sangre ABO
- tipo HLA
- radiografía de tórax
- electrocardiografía (ECG)
Donación de células madre de sangre periférica (PBSC)
Antes de que una persona pueda donar PBSC, deberá someterse a inyecciones diarias de un medicamento llamado filgrastim en los cinco días previos al procedimiento. Este medicamento extrae células madre de la médula ósea, por lo que el donante tendrá más de ellas circulando en su sangre.
Donar PBSC implica un procedimiento conocido como aféresis. Esto ocurre cuando se extrae sangre del cuerpo mediante un catéter insertado en un brazo y se pasa a través de una máquina, filtrando las células madre, junto con las plaquetas y los glóbulos blancos. La sangre restante (que consiste principalmente en plasma y glóbulos rojos) luego regresa al cuerpo a través de una vena en el otro brazo.
El procedimiento es completamente indoloro y es similar a donar plasma. La donación de PBSC generalmente requerirá entre dos y cuatro sesiones, cada una de 2 a 6 horas.
La donación de PBSC no requiere anestesia. El medicamento que se administra para estimular la movilización (liberación) de células madre de la médula hacia el torrente sanguíneo puede causar dolores en los huesos y músculos, dolores de cabeza , fatiga , náuseas, vómitos o dificultad para dormir. Estos efectos secundarios generalmente se detienen dentro de los 2 a 3 días de la última dosis del medicamento.
Donar médula ósea
Si una persona está donando médula ósea real en lugar de PBSC, no hay necesidad de las inyecciones de filgrastim. La donación de médula ósea es un procedimiento quirúrgico que se realiza en el quirófano, que requiere anestesia y, por lo tanto, es totalmente indoloro. Todo el procedimiento dura entre 1 y 2 horas.
En el 96 por ciento de los casos, se utiliza anestesia general, lo que significa que el donante estará inconsciente durante todo el procedimiento.En un pequeño número de casos se utilizará un anestésico local, que simplemente adormece el área de la cual se extrae la médula ósea. En esta situación, la persona estará despierta durante todo el procedimiento.
La persona se acuesta sobre su estómago. Los médicos realizarán una incisión de aproximadamente un cuarto de pulgada de largo en ambos lados del hueso pélvico. Luego insertan agujas especiales y huecas en el hueso, a través de las cuales extraen la médula líquida. Las incisiones normalmente no requieren puntos de sutura.
Después del procedimiento, el donante permanecerá en una sala de recuperación hasta que recupere la conciencia. Una vez que puedan comer, beber y caminar, podrán irse.
Recuperación
Después de la donación, la recuperación completa puede tardar un par de días, especialmente si hubo cirugía.
Las personas que donan médula ósea a menudo experimentan dolores de cabeza, fatiga, dolores musculares, dolor de espalda o cadera, moretones en el lugar de la incisión y dificultad para caminar. Esto puede durar hasta 2 días, o hasta varias semanas.
Es poco probable que una persona que dona PBSC experimente algún efecto secundario después de la donación, aparte de los moretones en el sitio de la aguja. El tiempo de recuperación es casi inmediato.
Después de la donación, la médula ósea se reemplaza a sí misma dentro de 4 a 6 semanas.
Salir
El resultado del trasplante de médula ósea depende de:
- el tipo de trasplante
- qué tan cerca coinciden las células
- qué tipo de condición tiene el paciente
- la edad y salud general del paciente
- el tipo y la dosis de quimioterapia o radioterapia utilizada antes del trasplante
alguna complicación
Un paciente cuya condición es estable o en remisión tiene una mejor probabilidad de un buen resultado en comparación con alguien que tiene un trasplante en una etapa posterior o con una enfermedad recurrente. La edad temprana en el momento del trasplante también mejora las posibilidades.
Los trasplantes para enfermedades no malignas tienden a tener resultados más favorables, con una tasa de supervivencia del 70 al 90 por ciento si el donante es un hermano compatible, y del 36 al 65 por ciento si el donante no está relacionado.
Los trasplantes para la leucemia aguda en remisión en el momento del trasplante tienen tasas de supervivencia del 55 al 68 por ciento si el donante está relacionado y del 26 al 50 por ciento si el donante no está relacionado.
Un trasplante de médula ósea puede curar total o parcialmente la enfermedad. Si el trasplante es exitoso, los individuos pueden regresar a la mayoría de las actividades normales tan pronto como se sientan lo suficientemente bien. La recuperación completa normalmente toma hasta un año.
Referencias:
- Enciclopedia británica, médula ósea , consultada el 14 de noviembre de 2014. http://www.britannica.com/EBchecked/topic/72944/bone-marrow
- Medscape, Tipos de médula ósea , última actualización 22 de agosto de 2013, consultado el 14 de noviembre de 2014. http://emedicine.medscape.com/article/1968326-overview#aw2aab6b3
- Science Daily, artículo de referencia – médula ósea , consultado el 14 de noviembre de 2014. http://www.sciencedaily.com/articles/b/bone_marrow.htm
- Instituto Nacional del Cáncer, trasplante de médula ósea y trasplante de células madre de sangre periférica , consultado el 14 de noviembre de 2014. http://www.cancer.gov/cancertopics/factsheet/Therapy/bone-marrow-transplant
- Johns Hopkins Medicine, Conceptos básicos sobre el cáncer de la sangre y la médula ósea , consultado el 14 de noviembre de 2014. http://www.hopkinsmedicine.org/kimmel_cancer_center/centers/blood_bone_marrow_cancers/blood_bone_marrow_cancer_basics.html
- Sociedad para la inmunología, médula ósea , consultado el 14 de noviembre de 2014. http://bitesized.immunology.org/organs-and-tissues/bone-marrow
- Explore Stem Cells, cosecha de células madre de médula ósea , consultado el 14 de noviembre de 2014. http://www.explorestemcells.co.uk/bonemarrowstemcellharvest.html
- Cancer.net, Donación de médula ósea , consultado el 14 de noviembre de 2014. http://www.cancer.net/navigating-cancer-care/diagnosing-cancer/tests-and-procedures/donating-bone-marrow
- Centros para el Control y Prevención de Enfermedades (CDC), trasplante de células madre (médula ósea) , consultado el 14 de noviembre de 2014. http://www.cdc.gov/ncbddd/dba/stem.html
- Paciente, trasplante de células madre , última actualización 15 de octubre de 2014, consultado el 14 de noviembre de 2014. http://www.patient.co.uk/health/stem-cell-transplant
- Fundación del síndrome mielodisplásico, ¿qué hace mi médula ósea? Accedido el 14 de noviembre. http://www.mdspatientsupport.org.uk/wp-content/uploads/2012/07/What-does-my-bone-marrow-do.pdf
- Enciclopedia de cirugía, trasplante de médula ósea , consultado el 14 de noviembre de 2014. http://www.surgeryencyclopedia.com/A-Ce/Bone-Marrow-Transplantation.html
- Medscape, formación de células sanguíneas , actualizado el 22 de agosto de 2013, consultado el 14 de noviembre de 2014. http://emedicine.medscape.com/article/1968326-overview#aw2aab6b4
- Macmillan, El sistema linfático , consultado el 14 de noviembre de 2014. http://www.macmillan.org.uk/Cancerinformation/Cancertypes/LymphomaHodgkin/AboutHodgkinlymphoma/Thelymphaticsystem.aspx
- Medscape, barrera de vasos sanguíneos y compartimentación , actualizado el 22 de agosto de 2013, consultado el 14 de noviembre de 2014. http://emedicine.medscape.com/article/1968326-overview#aw2aab6b6
- Eliminar Cáncer de sangre, Acerca del cáncer de sangre , consultado el 14 de noviembre de 2014. http://www.deletebloodcancer.org/en/about-blood-cancer
- Medscape, trasplante de células madre hematopoyéticas , actualizado el 31 de marzo de 2014, visitado el 17 de noviembre de 2014. http://emedicine.medscape.com/article/208954-overview
- Medscape, anatomía de la médula ósea: examen de médula ósea , actualizado el 22 de agosto de 2013, visitado el 17 de noviembre de 2014. http://emedicine.medscape.com/article/1968326-overview#aw2aab6b8
- WebMD, trasplantes de médula ósea y trasplantes de células madre para el tratamiento del cáncer , consultado el 17 de noviembre de 2014. http://www.webmd.com/cancer/bone-marrow-transplants-stem-cell-transplants-cancer-treatment?page=2
- Medscape, trasplante de médula ósea: el proceso de búsqueda , actualizado el 7 de noviembre de 2014, acceso el 17 de noviembre de 2014. http://emedicine.medscape.com/article/1014514-overview#aw2aab6b5
- Medline, trasplante de médula ósea , consultado el 17 de noviembre de 2014. http://www.nlm.nih.gov/medlineplus/ency/article/003009.htm
- Trasplante de células madre hematopoyéticas en talasemia de células principales y falciformes: indicaciones y recomendaciones de manejo de un panel de expertos internacionales , E. Angelucci et al., Haematologic , doi: 10.3324 / haematol.2013.099747, publicado en mayo de 2014, publicado el 28 de septiembre de 2015. http://www.haematologica.org/content/99/5/811
- BMDW.org, Estadísticas: registros de donantes de células madre , consultados el 28 de septiembre de 2015. http://www.bmdw.org/index.php?id=statistics_stemcell
- BMDW.org, Estadísticas: registros de sangre de cordón umbilical , consultados el 28 de septiembre de 2015. http://www.bmdw.org/index.php?id=statistics_cordblood
- Etiquetas
- médula ósea
